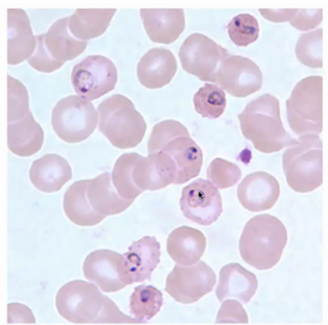

Paludisme (ou Malaria) : Tout ce qu'il faut savoir sur la maladie !
Le paludisme, également appelé « Malaria », est une maladie transmissible causée par un parasite (plasmodium falciparum, vivax, ovale ou malariae). Cette maladie est généralement transmise par le moustique (anopheles), qui se contamine lui-même en piquant une personne contaminée.
Si une personne contaminée n’est pas prise en charge rapidement, le risque de décès est important, c’est pourquoi les analyses biologiques de dépistage sont réalisées en urgence.
Le paludisme touche une centaine de pays dans le monde, particulièrement les zones tropicales défavorisées d’Afrique, d’Asie et d’Amérique Latine. La région Africaine est, de loin, la plus touché avec 94% des cas de paludisme recensés dans cette région. Des épidémies peuvent survenir lors de mouvements de populations peu exposées au paludisme vers des zones hautement endémiques.
En cas de voyage, il faudra donc prendre des précautions particulières afin de ne pas se contaminer.

Symptômes

Chez un sujet non immunisé le paludisme débute, 8 à 30 jours après la piqûre infectante, par une fièvre qui peut s’accompagner - ou non - de maux de tête, de douleurs musculaires, d’un affaiblissement, de vomissements, de diarrhées, de toux. Des cycles typiques alternent fièvre, tremblements et transpiration intense : on parle d’accès palustre.
Ces symptômes sont causés par la multiplication des parasites dans les globules rouges, ce qui les fait éclater, en entrainant une anémie.
Aucun symptôme n’étant spécifique de la maladie, devant tout patient symptomatique au retour de zone endémique, des tests diagnostiques spécifiques du paludisme doivent être réalisés en urgence afin d’affirmer ou d’éliminer cette hypothèse.
Bien que cela soit rare, il est également possible de contracter le paludisme en réalisant un transit dans une gare d’un pays endémique, ou en habitant à proximité d’un aéroport.
Le cycle de Plasmodium
Il comporte deux étapes essentielles : une phase asexuée chez l’homme, et une phase sexuée chez le moustique.
1- Tout commence avec un premier moustique femelle contaminé.
2- Lorsque ce moustique pique une personne, il lui injecte le parasite sous forme de « sporozoïte».
3- Celui-ci migre rapidement vers le foie via la circulation sanguine. Il pénètre dans les cellules du foie, où il se divise très activement pour donner naissance, en quelques jours, à des dizaines de milliers de nouveaux parasites.
4- La cellule du foie éclate en libérant ces mérozoïtes dans le sang, ils pénètrent alors à l’intérieur des globules rouges et se multiplient. Lorsque ces derniers éclatent à leur tour, les parasites sont libérés dans la circulation sanguine et infectent de nouveaux globules rouges. Après quelques cycles de réplication des mérozoïtes, des parasites sexués mâles et femelles (gamétocytes) se créent dans les globules rouges.
5- Lorsqu’un second moustique pique une personne infectée, il ingère ces gamétocytes, qui se transforment en gamètes. Leur fécondation engendre un zygote, qui se différencie en oocyste (œuf) dans le tube digestif du moustique. Les oocystes produisent des sporozoïtes, qui migrent vers les glandes salivaires du moustique.
6- Lorsque le moustique, porteur d’œuf dans sa salive, pique une nouvelle personne, il la contamine au paludisme et si un autre moustique pique cette personne, il se contaminera et sera porteur de la maladie…

Diagnostic
Le diagnostic de la contamination au parasite « plasmodium falciparum » se réalise très simplement à l’hôpital ou en laboratoire d’analyse.
Deux tests peuvent être réalisés :
- Le test de la goutte épaisse; une goutte de sang est prélevée par voie veineuse ou par piqûre à la pulpe du doigt, et permet de déterminer si le parasite plasmodium est présent dans l’organisme. Cette goutte est ensuite étalée sur une lame puis observée au microscope. Sur un échantillon contaminé, on peut apercevoir des amas violets dans les globules rouges, témoins de la présence du parasite. Cf image
- Une sérologie, qui permet de rechercher la présence d’anticorps ; afin de confirmer que le patient développe la maladie.
Ces tests sont considérés comme urgents car la maladie évolue rapidement, les résultats vous seront donc communiqués en moins de 12h.
Prévention
Lors d’un voyage en zone endémique, il est nécessaire de suivre une chimio-prophylaxie ; ces médicaments sont à prendre tous les jours pendant toute la durée du séjour, puis pendant les 4 semaines qui suivent le retour.
Pour info : depuis octobre 2021, il existe un vaccin qui protège contre les formes graves de paludisme. Cependant, il n’est disponible pour le moment qu’aux enfants entre 5 et 15 mois vivant en zone endémique.
Derniers articles
La Thyroïde : cet organe mal connu mais primordial
23/05/2022Lorsque le cerveau reçoit un stimulus lui indiquant qu’il faut produire des hormones, l’hypothalamus envoie un signal à l’hypophyse, qui produit de la TSH, qui est envoyée à la Thyroïde afin de l’activer. Dès que la thyroïde reçoit cette information, elle transformera de l’iode en hormones thyroïdiennes. Lors d’un dysfonctionnement thyroïdien, on observera des troubles de la synthèse hormonale.
La maladie de Lyme, qu'est-ce-que c'est ?
27/06/2022Tout savoir sur la maladie de Borréliose de Lyme : signes cliniques, traitement, test de dépistage par prise de sang, prévention... La maladie de Lyme, ou Borréliose de Lyme, est une zoonose fréquente transmissible par les tiques (Ixodes Ricinus). Lors de leur passage progressif sur des animaux sauvages, les tiques peuvent se contaminer par des maladies du sang, comme la borréliose de Lyme, puis infecter ensuite l’Homme.
Les hépatites, c’est quoi ?
01/08/2023Les hépatites virales sont classées de A à E en fonction de la famille du virus en cause. Leur principal point commun est leur capacité à infecter les cellules du foie et à s'y multiplier. Face à cette infection, le système immunitaire de l'hôte réagit, entraînant une destruction des cellules infectées et une inflammation (hépatite). Camille Lebreton, Biologiste Médical chez Eurofins.
Cancer de la prostate
13/09/2022Le cancer de la prostate c'est le premier rang des cancers incidents chez les hommes, 2e dans la population totale, 3e pour la mortalité. 60 000 nouveaux cas/an et 9 200 décès. Pathologies, diagnostic, facteur de risque ? On vous dit tout !


 Patients
Patients
 Professionnels
Professionnels
 Fertilité
Fertilité


























